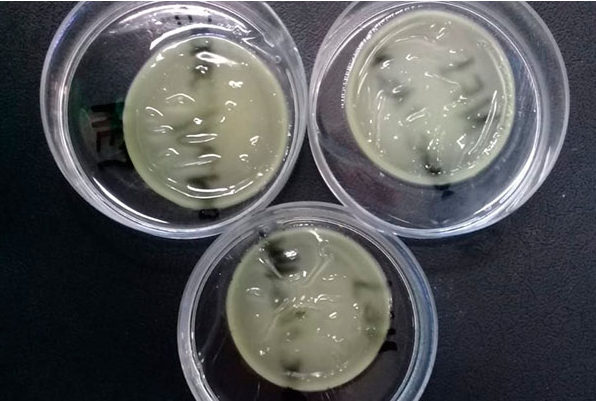

Ferimentos na pele são sempre desagradáveis. Sejam cortes, escoriações ou queimaduras, tais lesões exigem tratamentos analgésicos, anti-inflamatórios e de proteção da área que também costumam ser bem incômodos. Porém uma pesquisa do Faculdade de Farmácia da UFRN trabalha em um produto para melhorar esses cuidados.
Intitulado Curativos com novo ativo amazônico para o tratamento de lesões cutâneas, o projeto é do Grupo de Pesquisa Inovação em Fármacos e Medicamentos (Inofarm), coordenado pelo professor do Programa de Pós-Graduação em Ciências Farmacêuticas e do Departamento de Farmácia, Ádley Antonini Neves de Lima.
De acordo com o professor, o projeto consiste na criação de um curativo à base de um biopolímero que é biodegradável. Com isso, após ser aplicado à área lesionada da pele, não é necessária a remoção ou a troca sistemática, pois o próprio organismo absorve o produto com o passar dos dias.

Além disso, ao contrário de produtos amplamente difundidos e consolidados no mercado, como o band-aid, esse curativo não tem função meramente protetora da lesão. Uma vez em contato com o ferimento, ele libera uma substância derivada de uma planta amazônica que combate possíveis inflamações e tem efeito cicatrizante.
“Esses curativos possuem um princípio ativo natural que é liberado de maneira gradativa no local da lesão na pele, além de já ser uma barreira protetiva contra contaminantes externos como poeiras e microrganismos”, explica o professor, ressaltando que o produto não deixa o local pegajoso e nem suja roupas como os cremes e pomadas usados atualmente.
Com patente já depositada na Agência de Inovação da UFRN (Agir), o curativo passou pelos testes necessários antes de ser aplicado a humanos e os resultados são bastante significativos. “Fomos acompanhado e obtivemos cicatrizações em dez dias nas lesões. A partir de agora entramos na fase dos testes clínicos”, informa Ádley.

O produto despertou interesse no mercado farmacêutico. Em edital nacional lançado pela empresa Emerge, entre 70 outros projetos, o do Inofarm foi um dos 16 selecionados para participar do Emerge Labs, programa voltado à estruturação de pesquisas científicas com intuito de potencializar seu valor de mercado, transformando-as em produtos.
No Emerge Labs, os cientistas participaram de mentorias nas quais, entre outras atividades, receberam treinamentos cujo objetivo foi levar os pesquisadores a desenvolver uma visão inovadora e empreendedora. Em agosto desse ano, no mesmo evento, o professor Ádley apresentou o produto para empresas farmacêuticas e cosméticas e recebeu convites para parcerias e transferência de tecnologia com gigantes do ramo, como a Johnson & Johnson.
“É exatamente isto o que queremos, levar o que fazemos para a sociedade, para fora da universidade. Conseguir na UFRN um produto o qual os pacientes possam usar, registrando-o na Anvisa [Agência Nacional de Vigilância Sanitária], é o nosso foco. Nosso objetivo é melhorar a qualidade de vida das pessoas”, afirma o professor.

Entre na discussão